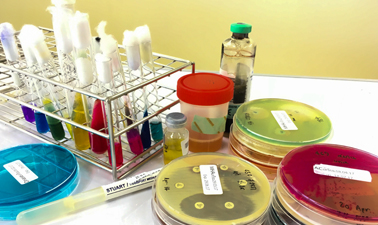

Laboratory Services
Clinical Bio-Chemistry
Our Biochemistry Department is headed by qualified Doctors and experienced Senior Technical staff. We use the state-of-art technologies such as CLIA and HPLC technologies for accuracy. The laboratory is equipped with fully automated analyzers with latest technology to perform the routine biochemical tests and also a wide range of specialized tests such as Hormonal assays, Tumor markers, Therapeutic Drug Monitoring, Infertility panel, Immunoglobulin's and many more.
Haematology
Our hematology department is headed by team of pathologists. The laboratory is equipped with fully automated cell counters for carrying out routine hematological investigations such as hemoglobin, total and differential leukocyte count, platelet count and red blood cell indices and automated coagulation analyzer.
Procedures like Bone marrow aspirations and Bone marrow biopsy are also done.
Microbiology
Our lab is equipped automated machine for blood culture, microbial identification and antibiotic susceptibility testing. We also offer on-site operation theater surveillance and fumigation protocols.
Histopathology & Cyto-pathology
The Histopathology department is headed by experienced team of pathologists to report all biopsies and specimens from specialties like General surgery, Gynaecology, Orthopedics, Respiratory Medicine, Urology, Gastro-intestinal, Cardiovascular, Neuropathology and Oncology.
Cyto-pathology includes all fluid cytologies, fine needle aspiration cytology and PAP Smears are also reported.
Prognostic markers like ER and PR receptor studies are routine reported on breast cancer cases. A wide range of IHC markers are available for the diagnosis and Management.
Procedures like Skin biopsy and Fine Needle Aspiration are done.
Home Collection Service
We at Shine Diagnostics and speciality lab recognize the difficulties faced by senior citizens / Bed ridden patients / people with busy schedules / to reach the laboratory. We provide services at doorstep for such people by sending our phlebotomist to their place of choice and collect samples/specimens.
For Home Collection Service, Just call us at 91-9652838387 or E-mail us at infoshine555@gmail.com.